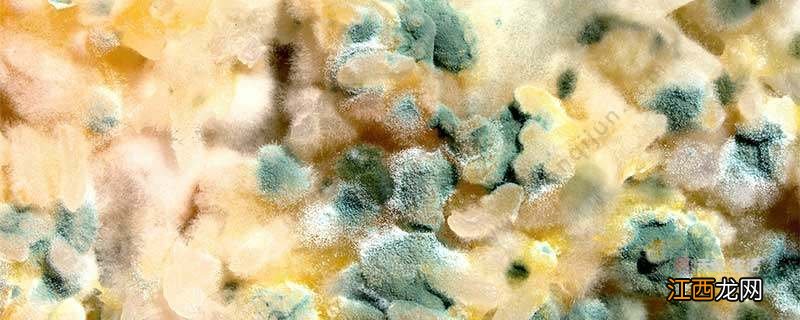
细菌菌落和真菌菌落的区别是什么 细菌菌落和真菌菌落怎么分辨
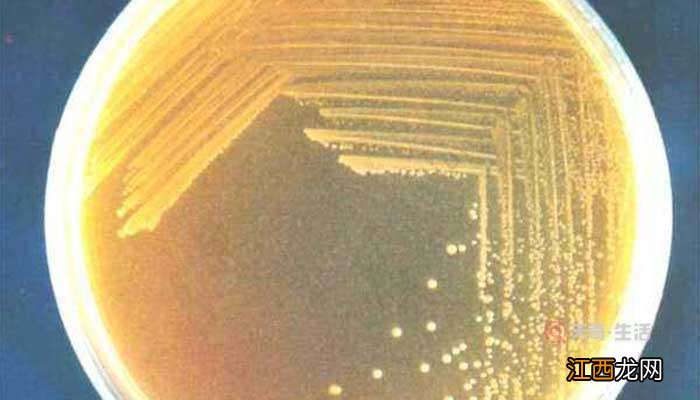
细菌菌落和真菌菌落的区别是什么 细菌菌落和真菌菌落怎么分辨

大小区别:细菌菌落一般较小,甚至是比较不起眼的;而真菌菌落明显会比细菌菌落大 。颜色区别:细菌菌落的颜色一般都比较淡和浅,多为白色、透明色、黄色;真菌菌落颜多且较深,常见的颜色有绿、黑、褐、黄、绿色等 。形态区别:细菌菌落表面光滑或粗糙,而真菌菌落的形状各式各样 。
文章插图
细菌菌落和真菌菌落的区别是什么
细菌菌落是肉眼可见的菌块,每一种细菌在一定条件下形成固定的菌落特征,不同种或同种在不同的培养条件下,其菌落特征是不同的 。同样的,真菌菌落也是肉眼可见的真菌菌落,和细菌菌落有着明显的区别,如下;
1、大小方面
细菌菌落一般较小,甚至是比较不起眼的;但真菌菌落,特别是霉菌落落是比较大的,非常的显眼的大小的对比 。两种菌落可以肉眼分辨谁是细菌菌落和真菌菌落 。
【细菌菌落和真菌菌落的区别是什么 细菌菌落和真菌菌落怎么分辨】
文章插图
2、颜色方面
细菌菌落一般是白色、透明色、黄色等,且基本上是比较淡和浅的颜色 。真菌菌落的颜色是多种多样的,常见的有绿、黑、褐、黄、绿色 。例如:霉菌菌落最常见颜色是绿色和黑色 。
3、形态方面
细菌菌落的表面要么是光滑黏稠,要么是粗燥干燥的,十分有特色,很容易分辨 。真菌菌落的形状各式各样,有蜘蛛网状的,有絮状的,还有绒毛样子的 。
相关经验推荐
- 玛德琳蛋糕的做法 玛德琳蛋糕的做法和配方视频
- 旅居和旅游的区别
- 如何清洗和保养帽子呢
- 如何清洗和保养小白鞋
- 如何去除衣服上的霉味和霉斑
- 山西板面和兰州拉面哪个好吃? 兰州拉面和安徽板面哪个受欢迎
- 怎么区分剑突和肿瘤呢
- 兔子肉炖什么绝配?兔子肉和啥肉炖好吃,看完一定要收藏了
- 冬天的就是寒冷的季节滑雪和温泉简直就是绝配
- 梨加什么治疗咳嗽最好?梨和什么熬治咳嗽最好,文章讲的好实用
